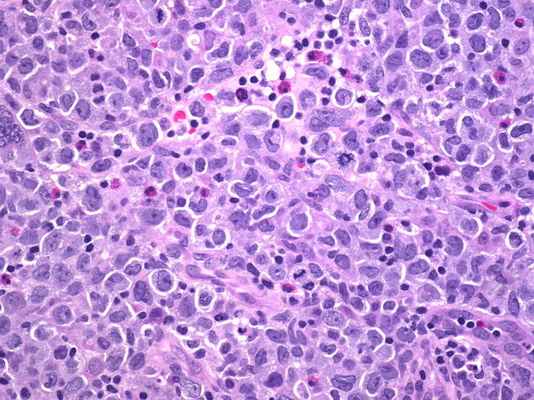
лечение лимфомы за рубежом

Лучевые признаки лимфомы яичника
Добавил пользователь Владимир З. Обновлено: 08.01.2026
Лимфома — злокачественная опухоль(рак лимфомы), которая поражает лимфатическую систему и клетки, являющиеся частью иммунной системы организма. По сосудам лимфатической системы циркулирует лимфа. Клетки лимфы, под названием лимфоциты, борются с инфекциями в организме, фильтруясь от бактерий в лимфатических узлах. Также лимфоциты находятся в иных лимфоидных тканях, например в селезенке, красном костном мозге, в коже.
Лимфома появляется, как и любой рак, когда клетки тела, в данном случае лимфоциты, начинают бесконтрольно делиться. Размножаясь, клетки собираются в лимфоузлах или в тканях других органов и образуют опухоль.
Болезнь выделяется двумя основными типами:
- болезнь Ходжкина или лимфома Ходжкина ( ходжкинская лимфома, лимфогранулематоз);
- остальные виды опухоли, такие как злокачественная лимфома кожи, с общим названием - неходжкинская лимфома.
У лимфом и ходжкинской лимфомы схожие симптомы, но они различаются поведением в организме, темпами распространения и реакцией на лечение. Исследуя злокачественные клетки под микроскопом, специалисты центра определят эти различия для постановки диагноза. Но в некоторых случаях может потребоваться сложный лабораторный тест для более точной дифференциальной диагностики.
Симптомы лимфомы
Симптомы у лимфом могут быть разными от случая к случаю и зависят от разных факторов: расположение очага, размеров и распространенности опухоли. Проявление на ранних стадиях может сопровождаться припухлостями на шее, в паху или подмышках. В области других скоплений лимфотканей могут появляться дополнительные очаги, например в селезенке.
При лимфоме Ходжкина симптоматика может сильно отличаться, в зависимости от области поражения лимфоузлов. Такие признаки как боли в спине, а иногда и потливость, лихорадка, быстрая потеря веса являются характерными симптомами появления лимфомы Ходжкина при изолированном поражении забрюшинных узлов. При опухоли лимфатических узлов легочных тканей, появляется скопление жидкости в плевральных полостях.
По причине увеличения лимфатических узлов, которые сдавливают кровеносные сосуды и нервы могут появиться такие симптомы как чувство покалывания или онемения, отек верхних и нижних конечностей. При сдавливании желудка может появиться быстрое насыщение при приеме пищи.
Лимфома Ходжкина
Лимфогранулематоз возникает как опухоль лимфатической системы средостроения из-за неправильного развития B-лимфоцитов. Существуют разные причины появления опухоли, но достоверно выявлены такие как: инфицированные вирусом Эпштейна-Барр и наследственность.
Лимфома Ходжкина разделяется на 4 гистологических варианта по иммунно-морфологическим характеристикам:
- смешанно-клеточная лимфома – встречается чаще всего, до 50% случаев;
- нодулярный (узловатый) склероз – вторая по частоте заболеваемости, до 45% случаев;
- лимфоидное истощение – до 10%;
- и наиболее редкая болезнь Ходжкина – богатая лимфоцитами (около 5%).
По международной клинической классификации TNM лимфома делится на 4 стадии с подразделением на А и B стадии.
Рецидивы при лимфоме Ходжкина
Ранние рецидивы могут возникнуть в первый же год после прохождения лечения, поздними называют рецидивы лимфомы Ходжкина, возникшие более чем через 12 месяцев после лечения. Такое подразделение по времени возникновения рецидива имеет значение в планировании дальнейшего лечения и прогнозирования результатов.
Диагностика лимфомы Ходжкина
Установить диагноз «лимфома» можно исключительно после проведения гистологических исследований тканей, полученных в результате проведения биопсии лимфатического узла или опухоли. Методы постановки диагноза:
- биопсия лимфатического узла;
- общий и биохимический анализ крови;
- рентгенография легких;
- компьютерная томография средостения;
- УЗИ;
- сканирование костей, при показаниях – рентгенография.
Диагноз считается достоверным, если в ходе гистологического исследования обнаружены специфические многоядерные клетки Штенберга.
Прогнозы при лимфоме Ходжкина
На сегодняшний день у прошедших лечение пациентов выживаемость в течение 20 лет приближается к 90%, у пациентов с распространенными стадиями заболевания – около 60%. Исходя из этого, прогнозы у пациентов с локальными стадиями можно считать достаточно хорошими в современной медицине.
Лимфома кожи
Неходжкинская лимфома, которая возникает только в коже и не поражает другие органы и ткани, называется лимфомой кожи. Заболевание исходно появляется в коже. Болезнь, которая распространяется на кожу после появления опухоли в лимфоузлах или других органах и тканях, относится к другой группе неходжкинских лимфом.
Клинически лимфома кожи делится на I, II и III степени злокачественности. По международной TNM-классификации выделяют стадии: IA и IB, IIA и IIB, III, IVA и IVB.
Т-клеточная лимфома или грибовидный микоз – самая частая форма опухоли кожи, примерно 70-80% заболеваний. Т-клеточная лимфома появляется в виде медленно развивающихся на верхних слоях дермы пятен и бляшек. Чаще всего болезнь поражает мужчин пожилого возраста (старше 50 лет), женщины подвержены заболеванию вдвое реже. Диагноз может быть поставлен более чем через 5 лет после появления, так как такая лимфома кожи имеет вялотекущий характер.
Реже, примерно в 20% заболевания, встречаются B-клеточные лимфомы. Они обычно растут постепенно в подкожной клетчатке и глубоких слоях дермы, опухолевым или солитарным узлом (узлами).
Тип лимфомы определяется в зависимости от вида лимфоцитов, чье злокачественное деление вызвало болезнь. Главной причиной злокачественного размножения лимфоцитов являются ретровирусы, но так же лимфому способны вызвать радиация, хронические инфекции, инсоляция и длительное воздействие химических раздражителей на кожу.
Лечение и прогнозы на выздоровление, а так же течение болезни значительно отличаются, в зависимости от формы Т-клеточной и В-клеточной лимфомы кожи. Наиболее благоприятный прогноз приходится на: классический грибовидный микоз (на ранних стадиях), педжетоидный редикулез, лимфоидный папулез, т-клеточную гамма/дельта-позитивную лимфому кожи.
Симптомы лимфомы кожи
У лимфомы кожи характерными признаками являются темные красные пятна на коже, узлы и "вздутые" бляшки, а также зуд и увеличение периферических лимфатических узлов. В редких случаях заболевание может напоминать псориаз: из-за узелков, образующих бляшки, шелушится кожа. Наиболее крупные узелки позднее поддаются некрозу. Формы лимфомы кожи: узелковая, бляшечная и эритродермическая. Степени злокачественности: I, II и III.
Кожная лимфома может проявиться и такими неспецифическими симптомами как:
- лихорадка с ознобами;
- необъяснимое снижение веса;
- ночная потливость;
- сонливость и зуд кожи.
Лимфомы средостения (опухоли лимфотических узлов в грудной области) часто проявляют себя одышкой, болью в груди, кашлем, лихорадочным состоянием, синей окраской кожи и слизистых оболочек.
Лечение лимфомы Ходжкина
На ранних стадиях заболевания обычно применяется химиотерапия как самостоятельный метод лечения, либо в сочетании с лучевой терапией. В отдельных редких случаях для лечения лимфомы Ходжкина самостоятельно может применяться радиотерапия. В любом случае пациент должен обязательно проходить лечение в специализированном медицинском центре под наблюдением врачей-онкологов, радиологов и хирургов.
Лучевая терапия проводится с целью уничтожения злокачественных клеток лимфомы с минимальными побочными эффектами, что обеспечивает максимальные шансы на излечение от рака. Во время процедуры происходит облучение опухоли пучком рентгеновских лучей высокой энергии, поток высвобождается в области патологического очага. Гибель клеток рака происходит только при непосредственном воздействии излучения на них, находящиеся вне поля воздействия луча клетки не уничтожаются. Исходя из этого, лучевая терапия является методом местного лечения, в отличие от химиотерапии.
Постоянное улучшение методов лечения лимфомы Ходжкина сокращает риски развития долгосрочных осложнений. Исследования позволяют сделать основной упор на долю химиотерапии с одновременным снижением лучевой нагрузки на организм.
Лучевая терапия при лимфоме Ходжкина
Для выработки высокоэнергетического внешнего излучения, способного проникнуть сквозь ткани и высвободить энергию в области злокачественной опухоли, используются специальные линейные ускорители. Онкологам-радиологам удается существенно снизить влияние побочных эффектов от радиотерапии при лечении лимфомы Ходжкина за счет современного оборудования и других передовых технологий.
Моделирование
Моделирование лучевой терапии при лимфоме Ходжкина является следующим этапом после первичной консультации пациента с онкологом-радиологом. Для проведения более точного лечения специалисты определяют нужные границы зон облучения и необходимые параметры предстоящей лучевой терапии. По сравнению с другими сеансами радиотерапии, когда происходит непосредственно облучение, этап моделирования занимает больше всего времени.
Во время процедуры пациент располагается на специальном столе, напоминающем кушетку КТ-сканера, который имеет возможность менять положение. Специальное оборудование, используемое для моделирования, имеет сходные с линейным ускорителем размеры и возможности перемещения вокруг стола. Однако оно предназначено для изучения области злокачественного новообразования, но не для рентгеновского облучения с целью лечения лимфомы.
Оценить анатомическое строение костной системы позволяет флюороскопия, которая проводится совместно с моделированием. А при использовании контрастного материала специалист может увидеть почки, кишечник, мочевой пузырь или пищевод.
Чтобы определить поля облучения, в процедурном кабинете периодически приглушается свет. Во время процедуры на кожу пациента могут наноситься временные отметки специальным маркером-фломастером. В процессе моделирования также участвуют несколько технологов и дозиметрист, в чьи задачи входит помощь онкологу-радиологу и подсчет необходимых параметров излучения.
По времени моделирование лучевой терапии может занимать от 15 до 60 минут, а порой и более, в зависимости от сложности конкретного случая лимфомы Ходжкина. Для отображения поля облучения после определения необходимых параметров излучения проводится рентгенография. Для того чтобы во время каждого сеанса специалист центра мог произвести точную настройку поля облучения, временные отметки на теле пациента заменяются на крошечные татуировки.
Комната для моделирования обычно располагается рядом с кабинетом, в котором будет проводиться непосредственно лечение. Разработанный в ходе моделирования план лучевой терапии переносится на компьютеры в процедурном кабинете и проверяется. Само лечение лимфомы Ходжкина лучевой терапией начинается после проверки онкологом-радиологом и технологом правильности расчетов и соответствия полей облучения назначенным параметрам радиотерапии.
Поля облучения
Поля облучения, которые определяются в процессе моделирования.
Облучение вовлеченных (пораженных) полей
Зона с лимфомой, включая прилегающие к опухоли лимфоузлы, всегда подвергается облучению лучевой терапией. Также на область расположения первичной опухоли может быть направлена дополнительная (бустерная) доза излучения.
Облучение мантиевидного поля
Облучению подвергаются пораженные ходжкинской лимфомой ткани средостроения, лимфатические пути шеи и подмышечных впадин, а так же легочная ткань. Проводится для обработки участка с самой опухолью и распространенных путей оттока лимфы. Во время процедуры онкологу-радиологу необходимо максимально защитить чувствительные к облучению ткани легких и молочных желез.
Облучение парааортальных полей
Проводится при поражении лимфатических узлов нижних отделов позвоночника, расположенных с обеих сторон от аорты и паховой области.
Облучение селезенки
Во времена, когда лучевая терапия являлась основным методом лечения лимфомы Ходжкина, проводилось удаление селезенки при ее поражении, а на область перевязанных кровеносных сосудов направлялись лучи. Проводилась лучевая терапия и без удаления органа, которая более актуальна с появлением эффективных вариантов комбинированной химиотерапии.
Режим лучевой терапии
Классический курс лучевой терапии состоит из ежедневных сеансов облучения в течение 3-5 недель, с понедельника по пятницу. Во время сеанса пациент не испытывает никакого дискомфорта, а процедура идет всего несколько минут.
На протяжении всего курса лечения болезни Ходжкина не применяются обезболивающие препараты. Нужно лишь на время курса ограничить физическую активность, хотя многие пациенты продолжают работать во время прохождения радиотерапии. Тем не менее, важно не перетруждаться и контролировать свое самочувствие.
Лучевая терапия при рецидиве
Радиотерапия при рецидиве лимфомы Ходжкина назначается с паллиативной целью, для снятия болевых симптомов и контроля. Но при локализованных рецидивах возможно применение лучевой терапии для воздействия на очаг опухоли переносимыми дозами излучения вплоть до излечения.
При неходжкинских лимфомах возможность использования облучения зависит от стадии и общего состояния здоровья больного. Радиотерапия использует воздействие ионизирующего излучения большой энергии для уничтожения злокачественной опухоли. Но у маленьких пациентов излучение может негативно сказаться на последующем развитии и росте.
Тотальное облучение лимфатических узлов
Тотальное облучение лимфоидной ткани подразумевает обработку лимфатических образований по всему телу. Такой метод применяется на поздних стадиях у пациентов с распространенными, прогрессирующими видами заболевания и не применяется на ранних стадиях медленнорастущих опухолей.
Тотальное облучение всего организма
Назначается тотальное облучение организма пациентам перед проведением высокодозовой химиотерапии с последующей трансплантацией стволовых клеток. При этом уничтожение злокачественных клеток опухоли обеспечивает рост и размножение клеток трансплантата. Профилактику отторжения пересаженных стволовых клеток в подобных случаях обеспечивает также лучевая терапия.
Стратегии увеличения эффективности лечения
Благодаря участию врачей и пациентов в различных клинических исследованиях удалось достигнуть прогресса в лечении лимфомы Ходжкина. Эти исследования привели к использованию комбинированного химиолучевого лечения и более лучших методов проведения лучевой терапии.
Трехмерная конформная лучевая терапия
Трехмерная конформная радиотерапия является многообещающим методом, который позволяет уменьшить воздействие излучения на здоровые ткани.
Компьютеризированные методики сканирования позволяют снизить лучевую нагрузку на здоровые клетки на целых 50% за счет подведения высоких доз излучения непосредственно к опухоли. Таких результатов удалось добиться благодаря возможности определения трехмерных контуров и размеров злокачественного новообразования.
Лечение лимфомы кожи
Методы, используемые в лечении неходжкинсккой лимфомы:
- местная медикаментозная терапия (на ранних стадиях);
- лучевая терапия;
- химиотерапия;
- трансплантация костного мозга (его стволовых клеток);
- биологическая терапия (BRMT).
В лечении лимфомы кожи на сегодня очень хорошие результаты приносит системное лечение. Наиболее распространено комплексное использование лучевой терапии и химиотерапии. Назначается тот или иной метод лечения, разумеется, в зависимости от конкретного случая распространения рака после тщательной диагностики.
Многие виды биологической терапии по-прежнему находятся на экспериментальной стадии, но уже теперь результаты научных исследований позволяют надеяться, что с помощью этого метода возможно будет лечить не только неходжкинскую лимфому, но и многие другие виды рака.
Лимфома
Лимфома – это злокачественное заболевание, которое характеризуется поражением лимфатических узлов и внутренних органов, в которых скапливаются «опухолевые» лимфоциты.
Акции
Полное обследование на онкологические заболевания для мужчин и женщин.
Онкоконсилиум может потребоваться как при лечении в «СМ-Клиника», так и пациентам других медицинских учреждений с целью получения альтернативного мнения.
«СМ-Клиника» предоставляет своим пациентам предоперационное обследование со скидкой до 72%!
Консультация врача-хирурга по поводу операции бесплатно!
Содержание статьи:
Лимфома (lymphoma) – злокачественная опухоль клеток иммунитета.При ней лимфоциты увеличиваются до гигантских размеров, бесконтрольно делятся и поражают лимфатическую систему: лимфоузлы, костный мозг, вилочковую железу.
От других онкологических заболеваний лимфома отличается диссеминацией по всему организму: с током лимфы переродившиесязлокачественныеклетки попадают во внутренние органы и критически нарушают их работу. Болезнь долго течет бессимптомно, а когда начинает проявляться, то часто весь организм уже поражен.
Большинство лимфом характеризуется прогрессирующим течением и высокой злокачественностью с метастазированием. Тем не менее при раннем их выявлении благоприятный прогноз достигает ~90%.
Статистические данные о лимфомах:
- Ежегодно в России выявляют около 25 000 пациентов с раком данного типа – это 4% от всех онкобольных.
- Мужчины болеют чаще, чем женщины.
- Возрастной пик заболеваемости – 30-34 года и после 60 лет.
- В группе риска – больные с артритом двух и более суставов.
- Провоцирующий фактор – дефицит селена в организме.
- Есть предположение, что окрашивание волос чаще 1 раза в месяц темной краской увеличивают риск развития лимфомы на 26%.
- Считается что витамин Д обладает защитными свойствами против лимфомы.
- Благодаря современным методикам и препаратам за последние 10 лет смертность от лимфом в России снизилась на 27%.
Виды лимфом
Различают две основные группы заболевания – лимфому Ходжкина и неходжкинские лимфомы. Они развиваются из разного типа клеток, отличаются характером течения и по-разному реагируют на терапию.
Лимфома Ходжкина (ЛГМ) – лимфогранулематоз, злокачественная гранулема.ХарактеризуетсяпоражениемВ-лимфоцитов. Отличается агрессивным течением, при этом хорошо поддается лечению Источник:
И.И. Яковцова, В.Д. Садчиков, В.М. Садчикова, О.В. Долгая, С.В. Данилюк, А.Е. Олейник Лимфома Ходжкина: эволюция клинических классификаций // Вестник проблем биологии и медицины, 2013, №3, т.2 (103), с.62-69 .
Неходжкинские лимфомы (НХЛ)поражают не только В-, но и Т-лимфоциты. Всего выделено 30 подтипов.Большинство из них менее агрессивно, но и труднее лечится.
Классификация неходжкинских лимфом в соответствии с 4-й редакцией ВОЗ 2008 года:
- В-лимфобластная НХЛ;
- болезнь тяжелых цепей;
- В-клеточный пролимфоцитарный лейкоз;
- волосатоклеточный лейкоз;
- диффузная В-крупноклеточая НХЛ;
- лейкоз Беркитта;
- НХЛ из клеток мантийной зоны;
- лимфоплазмоцитарная НХЛ;
- медиастинальная диффузная В-крупноклеточая НХЛ;
- нодальная В-клеточная НХЛ маргинальной зоны;
- первичная экссудативная НХЛ;
- плазмоклеточная плазмоцитома/миелома;
- селезеночная НХЛ маргинальной зоны;
- фолликулярная НХЛ;
- хронический лимфолейкоз;
- экстранодальная В-клеточная НХЛ маргинальной зоны;
- Т-лимфобластная НХЛ;
- агрессивный NK-клеточный лейкоз;
- анапластическая крупноклеточная НХЛ с первичным поражением кожи;
- анапластическая крупноклеточная НХЛ с первичным системным поражением;
- ангиоиммунобластная Т-клеточная НХЛ;
- гепатолиенальная Т-клеточная НХЛ;
- грибовидный микоз Сезари;
- неуточненная периферическая Т-клеточная НХЛ;
- Т-клеточная панникулитоподобная НХЛ подкожной клетчатки;
- Т-клеточный лейкоз;
- Т-клеточный лейкоз из больших гранулярных лимфоцитов;
- Т-клеточный пролимфоцитарный лейкоз;
- экстранодальная NK/T-клеточная лимфома назального типа;
- энтеропатическая Т-клеточная НХЛ.
По характеру поражения и патогенезу все лимфомы делятся на 3 основные группы:
- агрессивные – для них характерно быстрое развитие с ярко выраженной симптоматикой;
- экстранодальные – первичное поражение формируется не в лимфатических узлах, а сразу во внутренних органах;
- индолентные – отличаются своим медленным и благоприятным течением; могут не требовать терапии, иногда достаточно регулярно наблюдаться у врача.
Для каждого вида лимфом существует особая схема лечения.
Стадии лимфом
В зависимости от распространенности опухоли определяют стадию патологического процесса. В соответствии с международной классификацией AnnArborвыделяют 4 стадии заболевания:
- На 1-й стадии в лимфомный процесс может быть вовлечена одна группа лимфатических узлов.
- На 2-й допускается вовлечение двух и более групп по одну сторону от диафрагмы.
- На 3-й стадии опускается поражение лимфатических узлов по обе стороны диафрагмы.
- На 4-й стадии в процесс вовлекаются внутренние органы – мозг, сердце, печень, селезенка, желудок, кишечник.
Каждую стадию дополнительно маркируют титрами А и Б. Титр А указывает на отсутствие ключевых симптомов – лихорадки, сильной ночной потливости и резкого снижения веса. Титр Б указывает, что такие проявления есть.
Причины возникновения лимфом
Единого причинного фактора развития заболевания не выделено. На данный момент ученые считают, что патпроцесс запускается комплексом причин. К ним относят:
- наследственную предрасположенность;
- регулярные контакты с токсинами и канцерогенами;
- вирус герпеса, гепатита, хеликобактер пилори и другие инфекционные заболевания;
- аутоиммунные и иммунодефицитные состояния;
- повторяющиеся пневмонии;
- иммуноподавляющую терапию после пересадки почек, стволовых леток и т. д.;
- операции по вставке грудных имплантатов (предположительно).
Симптомы
Помимо основных симптомов – лихорадки, сильной ночной потливости и резкого снижения веса – для патологии характерны:
- слабость и повышенная утомляемость;
- повышение температуры;
- потеря веса;
- увеличение лимфатических узлов (часто, но не всегда; при этом они безболезненны и не уменьшаются в результате лечения антибиотиками, как при инфекционных заболеваниях).
Иногда возможен кожный зуд. При поражениях опухолью грудной клетки возможны затрудненное дыхание, одышка и кашель. При локализации новообразования в брюшной полости наблюдают расстройства пищеварения, тошноту, рвоту, распирающие боли в животе и нижней части спины. При поражении костного мозга больные жалуются на боли в костях.Если в патологию вовлечены лицевые и черепные структуры, есть жалобы на головные боли и распирающие боли в лице и шее.
Диагностика лимфом
Диагноз ставят по результатам микроскопического исследования биоптата – образца лимфоидной ткани. По результатам дифференциальной биопсии определяют тип опухоли.
Чтобы выявить опухоли в разных частях тела, применяют методы лучевой диагностики: рентгенографию, сцинтиграфию, магниторезонансную, позитронно-эмиссионную и компьютерную томографию. При необходимости уточнить некоторые особенности патпроцесса назначают лабораторные анализы крови – иммуноферментотипирование методом проточной цитометрии, молекулярно-генетические и цитогенетические исследования Источник:
Wang HW, Balakrishna JP, Pittaluga S, Jaffe ES Diagnosis of Hodgkin lymphoma in the modern era // Br J Haematol. 2019 Jan;184(1):45-59. doi: 10.1111/bjh.15614. Epub 2018 Nov 8 .
Методы лечения
Наиболее распространенные методы лечения лимфом:
- лучевая терапия;
- химиотерапия;
- радиотерапия;
- биологическая терапия;
- трансплантация стволовых клеток;
- хирургическое вмешательство.
Они применяются как в виде отдельных курсов, так и в комплексе. Выбор лечебной схемы зависит от вида опухоли и общего состояния больного.
Лечебная тактика
Индолентные лимфомы могут не требовать лечения, а только наблюдения онкогематолога. Терапия показана при первых признаках прогрессирования патпроцесса. При локализованных опухолях достаточно радиотерапевтического облучения пораженных структур. При генерализованных формах показана химиотерапия.
При агрессивном течении заболевания одна из наиболее эффективных лечебных схем – химиотерапия по протоколу СНОР в сочетании с иммунотерапевтическимипрепаратами из группы моноклональных антител. При высокоагрессивных видах опухолей может быть назначена высокодозная химиотерапия в сочетании с трансплантацией кроветорных стволовых клеток.
Лечение отдельных типов лимфом
Основной метод лечения лимфомы Ходжкина ЛГМ– химиотерапия. Противоопухолевые цитотоксины назначают в разных лекарственных формах. Химиотерапия носит цикличный характер – медикаментозные курсы чередуются с периодами реабилитации Источник:
Sermer D, Pasqualucci L, Wendel HG, Melnick A, Younes A Emerging epigenetic-modulating therapies in lymphoma // Nat Rev Clin Oncol. 2019 Aug;16(8):494-507.doi: 10.1038/s41571-019-0190-8 .
Радиотерапия – излучение высокой мощности – в качестве самостоятельного лечения ЛГМ может быть оправдана в отдельных случаях – когда в процесс вовлечена одна, максимум две группы лимфатических узлов. Чаще ее назначают в комплексе с химиотерапией. На поздних стадиях заболевания метод показан в качестве паллиативного лечения.
Биологические препараты – моноклональные антитела – при лечении лимфомы применяют для активизации иммунной системы. Лучевую терапию проводят регионарно, в области вовлеченных в онкологический процесс лимфоузлов.
В некоторых случаях при лечении ЛГМ оправдано удаление селезенки. Если увеличенные лимфатические узлы сдавливают соседние органы,может быть показано их иссечение.
При рецидивах заболевания, а также с целью уничтожения раковых клеток, на которые не действуют стандартные дозировки лучевой и химиотерапии, назначают высокие терапевтические дозы, разрушающие вместе с опухолью ткани костного мозга. После такого курса показана трансплантация органа. Взятые заранее собственные либо донорские стволовые клетки формируют новую иммунную систему.
Хорошие результаты в лечении НХЛ демонстрирует также комбинация лучевой и химиотерапии. В некоторых случаях успешно применяют инновационную техникулюмбально-пункционного введения противоопухолевых антител.
НХЛ с агрессивным течением плохо поддаются лечению. Наиболее эффективный метод борьбы с этим заболеванием – пересадка костного мозга.
Прогнозы
Прогноз для пациентов с лимфомами зависит от стадии процесса, возраста и состояния больного, а также от результатов терапии. При лимфоме Ходжкина пациенты молодого возраста на ранних стадиях,как правило, полностью выздоравливают. У 8 из 10 удается добиться устойчивой ремиссии. Пятилетняя выживаемость при 1-й стадии составляет 95%, при 4-й – 65%.
При НХЛ селезенки, лимфоузлов и слизистых средняя пятилетняя выживаемость – порядка 70%. При НХЛ ЖКТ, слюнных желез, глазных орбит средняя пятилетняя выживаемость – около 60%. Менее благоприятный прогноз у агрессивных НХЛ молочных желез, яичников, ЦНС и костей – пятилетняя выживаемость в среднем меньше 30%.
Клинические рекомендации после лечения лимфом и профилактика
Избегайте факторов риска – интоксикаций и контакта с канцерогенами. Вакцинируйтесь, а если заболели инфекционной болезнью – не занимайтесь самолечением.
При первых признаках лимфомы обращайтесь к врачу. Ежегодно проходите профилактические медосмотры, придерживайтесь правильного питания и старайтесь вести здоровый образ жизни.
Источники:
Михайлов Алексей Геннадьевич оперирующий онколог, врач высшей квалификационной категории, к.м.н. стаж: 21 год
Информация в статье предоставлена в справочных целях и не заменяет консультации квалифицированного специалиста. Не занимайтесь самолечением! При первых признаках заболевания необходимо обратиться к врачу.
Лимфома
Лимфома — опухоль, вызванная перерождением лимфоцитов — клеток лимфатической системы. Лечение назначается с учетом совокупности факторов, среди которых разновидность и размеры образования, состояние пациента, результаты предыдущей терапии, если она проводилась.
Использовать термин «рак» в данном случае некорректно, поскольку он относится к опухолям, образованным при мутации эпителиальных клеток, а лимфоциты в их число не входят. Однако по опасности для здоровья и жизни это заболевания одного порядка.

Нам доверяют 9500 пациентов ежегодно.
Симптомы и диагностика
- Увеличение лимфоузлов. Оно может быть безболезненным, но при обращении к врачу диагноз устанавливается быстро, что позволяет оперативно начать лечение.
- Повышение температуры без симптомов простудных или других заболеваний. Держится месяцами в районе 38°, не снижается при приеме антибиотиков и жаропонижающих средств.
- Сильная ночная потливость.
- Снижение веса.
Повышенная утомляемость, слабость часто сопровождают развитие опухолей. Когда образование увеличивается в размерах настолько, что давит на соседние ткани, органы, кровеносные сосуды, могут проявиться нарушения в работе других систем: рвота, головная боль, одышка, проблемы со зрением и т.д.
При диагностике используют визуальный осмотр и пальпацию, а также анализ крови, разные виды биопсии, УЗИ, КТ, МРТ, ПЭТ.
Заболевание встречается у детей и взрослых независимо от пола. Риски повышаются при некоторых инфекционных болезнях, иммунодефиците, первичном или вторичном. С лимфомами часто сталкиваются люди, больные ВИЧ, СПИДом, туберкулезом, гепатитами В и С, аутоиммунными заболеваниями либо принимающие подавляющие иммунитет препараты, например при пересадке органов. Играет свою роль и наследственность.
Классификация
Хотя разновидностей этих новообразований около сотни, выделяют две основные группы:
- Лимфома Ходжкина (лимфогранулематоз) — при ней в лимфатической системе появляются патологически крупные клетки. Прогнозы по выживаемости при этом диагнозе достаточно высокие, особенно если к лечению приступили на ранних стадиях.
- Неходжкинские лимфомы — все остальные виды. Их много, основное деление осуществляется по видам лимфоцитов, мутировавших в образовании: В-клеточные и Т-клеточные.
По тому, как развивается болезнь, выделяют:
- индолентные (доброкачественные) — прогрессируют медленно, однако плохо поддаются лечению: после удаления в скором времени наблюдается рецидив;
- агрессивные — быстро растут, требуют обязательного лечения;
- сверхагрессивные — без лечения приводят к летальному исходу за несколько месяцев.
Кандидат медицинских наук
Опыт работы: Более 19 лет
Лечение лимфомы
Как и у других онкологических заболеваний, выделяют 4 стадии лимфомы:
I — опухоль небольших размеров, имеет четкие границы, расположена в пределах одной группы лимфоузлов и в одном органе;
II — образования расположены по одну сторону диафрагмы;
III — опухоли распространились по обе стороны диафрагмы;
IV — задеты органы не лимфатической системы или костный мозг.
Лимфомы - виды, стадии, диагностика, лечение
Что такое лимфомы?
Лимфомы – это неоднородная группа злокачественных опухолей, происходящих из клеток крови лимфоцитарного ряда. Основная локализация этих опухолей – лимфатические узлы, однако в процесс могут вовлекаться внутренние органы и кости.
Что вызывает лимфомы?
Причина возникновения лимфом, собственно как и большинства других злокачественных новообразований, в настоящее время точно не известна. Факторами риска возникновения лимфом являются:
- Наследственность (высокий риск, если лимфомой больны родственники первой линии родства: отец или мать, брат или сестра).
- Генетические поломки (лимфомы в 25% случаев возникают у людей, больных некоторыми наследственными заболеваниями, например синдромом Вискотта-Олдрича, отдельные варианты иммунодефицита и т.д.)
- Аутоиммунные заболевания (ревматоидный артрит, системная красная волчанка)
- Инфекции (вирус Эпштейн-Барра, герпес вирус, вирус гепатита С и т.д.)
- Приобретенный иммунодефицит (СПИД, прием иммуносупрессоров).
Насколько распространены лимфомы?
Согласно данным медицинской статистики, лимфомы составляют около 4% от всех злокачественных опухолей. Заболеваемость различными видами лимфом по всему миру считается высокой. Наибольшее распространение этот недуг получил в: США, Дании, Новой Зеландии, странах СНГ. Среди детей заболеваемость выше в странах Африки и Среднего Востока.
Заболеваемость лимфомой Ходжкина в Украине составляет примерно 2,4 случая на 100000 населения. Отмечают два возрастных пика заболеваемости в 16-30 лет и старше 50 лет.
Заболеваемость неходжкинскими лимфомами в Украине составляет в среднем 4-5 случаев на 100000 населения.
Виды лимфом
Выделяют два основных класса лимфом:
- Лимфому Ходжкина
- Неходжкинскую лимфому
Лимфома Ходжкина или лимфогранулематоз – это злокачественное заболевание лимфатической системы, при котором в лимфатических узлах отмечается скопление атипичных лимфоцитов В класса. Измененные лимфоциты – многоядерные гигантские клетки, получили название клеток Рида-Березовского-Штернберга. Их предшественники – одноядерные клетки, называют клетками Ходжкина. Атипичные лимфоциты, а также клетки крови (нейтрофилы, тучные клетки, плазмациты и т.д.) представляют собой основной субстрат опухоли. Аномальные клетки могут распространяться с током крови или лимфы в другие части тела: внутренние органы и костную ткань.
В зависимости от морфологических изменений в лимфоидной ткани выделяют несколько вариантов лимфомы Ходжкина:
- Нодулярный склероз (до 50% всех лимфом Ходжкина)
- Смешанно-клеточный вариант (20-30%)
- Вариант, богатый лимфоцитами (до 15%)
- Лимфоидное истощение (менее 5%).
Важно! Обязательным диагностическим критерием является обнаружение в биопсийном материале (ткани лимфоузла) атипичных клеток Рида-Березовского-Штернберга.
Неходжкинские лимфомы. Основным субстратом неходжскинской лимфомы являются атипичные лимфоциты различного иммунологического класса: В или Т, основной локализацией которых является лимфоидная ткань, расположенная вне костного мозга. Лимфомы могут возникать у молодых людей, однако риск заболевания увеличивается с возрастом.
Существуют различные классификации неходжскинских лимфом.
В частности выделяют две основные линии неходжскинских лимфом: Т- и В-клеточные лимфомы, которые в свою очередь подразделяются на несколько типов (более 30 В-клеточных и более 20 видов Т-клеточных неходжскинских лимфом ).
По характеру течения выделяют неходжскинские лимфомы:
- Медленно развивающиеся (индолентные)
- Агрессивные
- Сверхагрессивные
Клинические проявления неходжскинских лимфом зависят от места первичной локализации опухоли и активности опухолевого роста. Неходжкинские лимфомы могут происходить из ткани лимфатических узлов – нодальный вариант (от nodus – узел), костного мозга – лейкемический вариант, внутренних органов – экстранодальный вариант.
Стадии развития лимфом
Заболевание имеет определенную стадийность. Критериями, определяющими стадии развития лимфом, являются: локализация опухоли и распространение ее за пределы первичной локализации. Стадию заболевания обозначают римскими цифрами: от I (ранняя стадия) до IV (распространенный рак).
Для определения стадии заболевания используют следующие методы исследования:
- Биопсия костного мозга
- Компьютерная томография (КТ)
- Магнитно-резонансная томография (МРТ)
- УЗИ
- Люмбальная пункция
- Позитронно-эмиссионная томография (ПЭТ КТ)
Лимфома Ходжкина
I стадия: клетки лимфомы Ходжкина находятся в одной группе лимфатических узлов. Крайне редко лимфома Ходжкина поражает нелимфоидные ткани, в такой ситуации: поражение одного органа или его части.
Стадия II: клетки лимфомы Ходжкина находятся в двух или более группах лимфоузлов на одной стороне (по одну сторону диафрагмы). Или, клетки лимфомы Ходжкина находятся в одном нелимфоидном органе и распространяются на, прилежащие к нему, лимфатические узлы.
Стадия III: клетки лимфомы Ходжкина находятся в лимфоузлах с обеих сторон диафрагмы. Или, в одном нелимфоидном органе, с вовлечением в процесс прилежащих лимфоузлов или селезенки.
Стадия IV: клетки лимфомы Ходжкина находятся в нескольких нелимфоидных органах, с поражением отдаленных лимфоузлов (по другую сторону диафрагмы).
Неходжкинская лимфома
Стадия I: клетки лимфомы находятся в одной группе лимфатических узлов (например, в области шеи или подмышки), или в одном нелимфоидном органе.
Стадия II: клетки лимфомы находятся в двух ли более группах лимфатических узлов на одной стороне (по одну сторону диафрагмы); или в одном органе и прилежащих к нему лимфоузлах.
Стадия III: клетки лимфомы находятся в лимфоузлах, расположенных, выше и ниже диафрагмы (возможно в сочетании с поражением селезенки); или поражение органов и тканей прилежащих к этим лимфоузлам.
Стадия IV: клетки лимфомы находятся в одном или нескольких нелимфоидных органах; или поражение одного нелимфоидного органа с вовлечением в процесс отдаленных от него лимфоузлов.
Диагностика
Онкомаркеры
Ряд лабораторных показателей специалисты используют для подтверждения и прогноза течения злокачественных новообразований. Такие показатели получили название онкомаркеров.
2-микроглобулин (2-МГ) является маркером, позволяющим прогнозировать и течение заболевания у пациентов с неходжскинской лимфомой. В норме находится на поверхности эпителиальных клеток и клеток крови. Биологическая роль ?2-МГ – участие в определенных иммунных реакциях. В норме концентрация в сыворотке крови составляет 0,6-2,5 мг\л. Значительное повышение показателя свидетельствует о прогрессе заболевания и коррелирует с плохим прогнозом. Оценка показателя производится специалистом, в совокупности с оценкой общего состояния и уровнем лимфоцитов в периферической крови.
Неоптерин – маркер активации клеточного иммунитета. Уровень неоптерина в крови может служить прогностическим показателем при злокачественных новообразованиях, в том числе при лимфомах Ходжкина. Нормальным показателем считается до 10 нмоль/л.
Дополнительные методы обследования
Иммуноморфологические методы исследования позволяют глубоко изучить особенности развития лимфом того или иного вида, а именно: точно определить разновидность лимфомы, изучить характер роста, степень дифференцировки клеток. Полученные данные позволяют подобрать максимально эффективную терапию.
Перед началом терапии может понадобиться проведение следующих диагностических мероприятий:
- Обследование органов сердечно-сосудистой и дыхательной системы. Проводится у пациентов с высоким риском развития побочных эффектов или осложнений от проводимого лечения.
- Консультация ЛОР врача. В первую очередь, пациентам, у которых отмечается поражение в области головы и шеи.
- Важным является решение вопроса о криоконсервации спермы или ткани яичников, у пациентов, которые планируют рождение детей в будущем. Химиотерапия и лучевая терапия могут привести к необратимой стерильности.
Лечение
Виды лечения
Лимфомы на ранних стадиях успешно поддаются терапии. В частности, на первой стадии лимфомы Ходжкина можно полностью излечить в 90% случаях. На IV стадии болезни удается достичь ремиссии у 50% больных, а в случае неходжскинских лимфом – у 30%.
Выбор метода лечения зависит от:
- Вида лимфомы
- Стадии заболевания
- Возраста
- Активности роста (для неходжскинских лимфом)
- Сопутствующих заболеваний
Лечение лимфом включает:
- химиотерапию (ХТ)
- лучевую терапию (ЛТ)
- хирургическое лечение
- использование биологических агентов: моноклональныхантител, интерферонов
- трансплантацию стволовых клеток.
Химиотерапия лимфом относится к системной терапии и заключается в приеме особых лекарственных средств, которые уничтожают раковые клетки. Препараты для химиотерапии принимают внутрь и вводят внутривенно. Выбор препарата и количество циклов химиотерапии, осуществляет врач, в зависимости от степени болезни и характеристик опухоли.
Побочными эффектами химиотерапии могут быть следующие:
- Угнетение кроветворения, что проявляется анемией, кровоточивостью, склонностью к инфекциям
- Выпадение волос
- Головная боль
- Снижение аппетита, тошнота, рвота.
Биологические методы лечения
Моноклональные антитела – это вещества белковой природы, синтезированные лабораторным путем, которые связываются с раковыми клетками и способствуют их уничтожению собственной иммунной системой.
Побочные эффекты возникают реже, чем при химиотерапии. Типичными побочными эффектами являются: головная боль и недомогание. Редко: слабость, низкое артериальное давление, сыпь на коже.
Лучевая терапия. Принцип лечения заключается в использовании радиоактивного излучения, уничтожающего раковые клетки.
Лучевая терапия в терапии лимфом бывает наружной и системной. При наружной терапии лучи направляют на область основного скопления раковых клеток. В ряде случаев приходится прибегать к системной лучевой терапии. Радиоактивный материал, связанный с моноклональными АТ, вводят в организм человека, больного лимфомой. Препарат мигрирует по организму и достигает отдаленных раковых клеток.
Побочными эффектами лучевой терапии являются:
- Изменения на коже
- Расстройства работы желудочно-кишечного тракта
- Чувство усталости и разбитости.
Лечение в зависимости от стадии
Лимфома Ходжкина
Начальные стадии (I-II стадия):
- 2-3 цикла полихимиотерапии по принятой схеме в комбинации с лучевой терапией.
I-II стадия, в сочетании с более чем 1 фактором риска (возраст старше 50 лет, поражение 4 и более групп лимфоузлов, симптомы интоксикации или высокое СОЭ)
- 4 цикла полихимиотерапии по схеме, в комбинации с лучевой терапией на зоны поражения.
- Полихимиотерапия по схеме + преднизолон + лучевой терапией. (соматически сохранным пациентам моложе 60 лет).
Распространенные стадии (III-IV):
- химиотерапия + лучевая терапия (если после химиотерапии остается большая масса опухоли)
- 6-8 циклов полихимиотерапии (4 препарата)
8 циклов полихимиотерапии (4 препарата) + преднизолон + лучевая терапия
Полихимиотерапия (4 препарата) + лучевая терапия (пациентам старше 60 лет).
Лечение в зависимости от стадии
Лимфома Ходжкина
Начальные стадии (I-II стадия):
- Лучевая терапия области опухолевого очага
- химиотерапия в сочетании с лучевой терапией
- лучевая терапия опухолевого очага и рядом расположенных лимфоузлов
- терапию моноклональными антителами в сочетании с химиотерапией или без нее.
I-II стадия неходжкинской лимфомы с агрессивным ростом:
- химиотерапия в сочетании с лучевой терапией области опухоли или без нее
- терапию моноклональными антителами в сочетании с химиотерапией, в сочетании со стероидными препаратами
- лучевая терапия
- химиотерапию в сочетании с назначением стероидных препаратов или без них
- терапию моноклональными антителами, в сочетании с химиотерапией или без нее
- терапию моноклональными антителами с радиоактивной меткой;
- лучевая терапия опухолевого очага и рядом расположенных лимфоузлов.
III-IV стадия неходжкинской лимфомы, с агрессивным ростом
- химиотерапия
- химиотерапия в сочетании с лучевой терапией, или терапией моноклональными антителами
- Может быть использована лучевая терапия
При рецидиве неходжкинской лимфомы проводят высокодозную химиотерапию, лучевую терапию, или сочетают эти методы лечения, с последующей трансплантацией стволовых клеток.
При неходжкинской лимфоме с медленным ростом (индолентные лимфомы) может быть выбрана тактика наблюдения. Пациент не получает никакого лечения, однако каждые три месяца приходит на консультацию и осмотр к лечащему врачу.
Наблюдение в дальнейшем
Даже после окончания лечения, пациент остается под наблюдением специалиста. Рекомендуется проходить обследование, включающее осмотр специалиста, лабораторные и инструментальные исследования каждые 3 месяца в течение первого года, каждые 6 месяцев в течение 4 лет, и в дальнейшем один раз в год.
При необходимости проводят исследование функции щитовидной железы. Регулярно проводят скрининг для исключения вторичных раковых заболеваний после лучевой терапии. Оценивают состояние сердечно-сосудистой и дыхательной системы для исключения отсроченных побочных эффектов от химиотерапии.
Лимфома Ходжкина (лимфогранулематоз)
Лимфомы – это разновидность злокачественных опухолей, поражающих прежде всего лимфатическую систему организма, состоящую из лимфатических узлов, объединенных системой мелких сосудов. При лимфоме в результате неограниченного деления "опухолевых" лимфоцитов их потомки заселяют лимфатические узлы и/или различные внутренние органы, вызывая нарушение их нормальной работы. Понятие «лимфома» объединяет более 30 заболеваний, различных по своим клиническим проявлениям, течению и прогнозу. Выделяют два основных типа лимфом: лимфома Ходжкина и неходжкинская лимфома.
Эпидемиология и демография
Лимфома Ходжкина (название введено ВОЗ в 2001 г., синонимы – лимфогранулематоз, болезнь Ходжкина) – это опухолевое заболевание лимфатической системы. Впервые описано Томасом Ходжкиным в 1832 г. Заболеваемость в России составляет 2,3 на 100000 населения. Болеют лимфомой Ходжкина люди любого возраста. Мужчины заболевают несколько чаще, чем женщины. До последнего времени полагали, что кривая заболеваемости имеет два пика – первый приходится на возраст 15-40 лет, а второй постепенно нарастает после 50 лет.
Однако использование иммунофенотипирования при пересмотре гистологических препаратов у больных старше 50 лет показало, что второй пик либо очень незначителен, либо полностью отсутствует, так как большая часть гистологических препаратов после ретроспективного анализа была отнесена к крупноклеточным неходжкинским лимфомам.
Заболевание, ранее бывшее неизлечимым, в настоящее время при своевременном выявлении и применении современных методик может быть излечено или достигнута стойкая ремиссия. Причины возникновения в настоящий момент окончательно не установлены. Описаны редкие случаи заболевания лимфомой в одной семье, однако лишь отдельные случаи фамильной лимфомы могут быть обусловлены наследственностью. В 1971 г. была выявлена зависимость между инфицированностью вирусом Эпштейна-Барр и частотой возникновения лимфомы.
В Международной морфологической классификации лимфом (ВОЗ, 2001 г.) по иммуно-морфологическим характеристикам выделено 4 гистологических варианта классической лимфомы Ходжкина:
- Богатый лимфоцитами (5-6% случаев)
- Нодулярный (узловатый) склероз (30-45%)
- Смешанно-клеточный (35-50%)
- Лимфоидное истощение – до 10%
Отдельно выделена небольшая группа больных, имеющая сходную с классической лимфомой Ходжкина морфологическую характеристику, но иную иммунологическую. Эта форма болезни получила название нодулярная с лимфоидным преобладанием лимфома Ходжкина. Течение этого варианта наиболее благоприятное.
Международная клиническая классификация делит лимфому Ходжкина на 4 стадии:
I – поражение одной группы лимфатических узлов или локализованное поражение одного экстралимфатического органа или ткани;
II – поражение двух и более групп лимфатических узлов под одну сторону диафрагмы;
III – поражение двух и более групп лимфатических узлов по обе стороны диафрагмы;
III1 – поражение отдельных лимфатических структур в верхней части брюшной полости (селезенки, лимфатических узлов ворот печени, чревных узлов);
III2 – поражение лимфатических узлов нижней половины брюшной полости (парааортальных, подвздошных и брыжеечных узлов);
IV – диффузное поражение различных внутренних органов.
Все стадии подразделяются на:
А – бессимптомное течение, нет признаков интоксикации;
В – необъяснимая потеря веса на 10%, беспричинная лихорадка свыше 38 градусов, ночные поты.
Рецидивы подразделяются на ранние (возникшие в течение первых 12 месяцев после окончания лечения) и поздние (возникшие более чем через 12 месяцев после окончания лечения). Такое разделение имеет большое значение при выборе интенсивности лечения рецидива и определении прогноза.
На ранних стадиях лимфома Ходжкина не имеет специфических признаков. Начинаясь в лимфатических узлах той или иной группы, патологический процесс может распространяться практически на все органы, сопровождаться различно выраженными симптомами интоксикации. Преимущественное поражение того или иного органа или системы и определяет клиническую картину заболевания. Первым проявлением лимфомы Ходжкина обычно становится увеличение лимфатических узлов; в 60-75% случаев процесс начинается в шейно-надключичных лимфатических узлах, несколько чаще справа. Как правило, увеличение периферических лимфатических узлов не сопровождается нарушением самочувствия больного.
Увеличенные лимфатические узлы подвижны, плотноэластичны, не спаяны с кожей, в редких случаях болезненны. Постепенно, а иногда быстро увеличиваясь, они сливаются в крупные конгломераты. У некоторых больных возникают боли в увеличенных лимфатических узлах после приема алкоголя.
У 15-20% больных лимфома Ходжкина начинается с увеличения лимфатических узлов средостения. Это увеличение может быть случайно обнаружено при флюорографии или проявиться в поздние сроки, когда размеры конгломерата значительны, кашлем, одышкой и симптомами сдавления верхней полой вены (отечность и синюшность лица, одышка), реже – болями за грудиной.
В единичных случаях лимфома Ходжкина начинается с изолированного поражения параортальных (забрюшинных, расположенных вдоль позвоночника) лимфатических узлов. Больной жалуется на боли в области поясницы, возникающие главным образом ночью. У 5-10% больных лимфома Ходжкина начинается остро с лихорадки, ночных потов, быстрого похудания. Обычно в этих случаях незначительное увеличение лимфатических узлов появляется позднее; заболевание сопровождается ранней лейкопенией и анемией (малокровием).
В период развернутых проявлений лимфомы Ходжкина возможно поражение всех лимфоидных органов и всех органов и систем организма. Селезенка поражается у 25-30% больных с первой – второй клинической стадией, диагностированной до спленэктомии. Поражение вальдейерова кольца – миндалин и лимфоидной ткани глотки – при лимфоме Ходжкина наблюдается редко.
Наиболее часто помимо лимфатических узлов лимфома Ходжкина поражает легочную ткань. В легких возможен как инфильтративный рост из лимфатических узлов средостения, так и развитие отдельных очагов или диффузных инфильтратов, иногда с распадом и образованием полостей. Поражения легких могут не сопровождаться выраженными клиническими симптомами. Довольно часто при лимфоме Ходжкина обнаруживается скопление жидкости в плевральных полостях.
Как правило, это признак специфического поражения плевры, иногда видимого при рентгенологическом исследовании. При этом в плевральной жидкости обнаруживаются лимфоидные и ретикулярные клетки, а также клетки Березовского-Штернберга. Поражение плевры встречается обычно у больных лимфогранулематозом с увеличенными лимфатическими узлами средостения или с очагами в легочной ткани. Опухоль в лимфатических узлах средостения может прорастать в перикард, миокард, пищевод, трахею.
Костная система – столь же частая, как и легочная ткань, локализация заболевания (рентгенологически приблизительно у 20% больных) при всех гистологических вариантах. Чаще поражаются позвонки, затем грудина, кости таза, ребра, реже – трубчатые кости. Вовлечение в процесс костей проявляется болями, рентгенологическая диагностика обычно запаздывает. В единичных случаях поражение кости может стать первым видимым признаком лимфогранулематоза.
Специфическое поражение костного мозга может обусловить снижение количества лейкоцитов и тромбоцитов в крови, анемию или остается бессимптомным.
Поражение печени из-за больших компенсаторных возможностей этого органа обнаруживается поздно. Печень обычно увеличивается, повышается активность щелочной фосфатазы, снижается альбумин сыворотки. Желудочно-кишечный тракт, как правило, страдает вторично в связи со сдавлением или прорастанием опухоли из пораженных лимфатических узлов. Однако в отдельных случаях встречается поражение желудка и тонкой кишки. Процесс обычно затрагивает подслизистый слой, язвы не образуется.
Иногда встречаются поражения центральной нервной системы, главным образом спинного мозга. Они локализуются в мозговых оболочках и дают серьезные неврологические расстройства вплоть до полного паралича. Весьма часты при лимфоме Ходжкина разнообразные изменения кожи: расчесы, аллергические проявления, реже бывают специфические поражения кожи опухолью. Лимфома Ходжкина может поражать почки, молочную железу, яичники, вилочковую железу, щитовидной железу, мягкие ткани.
Лихорадка при лимфоме Ходжкина многообразна. Довольно часто встречаются ежедневные кратковременные подъемы температуры. Они начинаются с озноба, заканчиваются проливным потом, но обычно легко переносятся больным. Лихорадка на первых порах купируется индометацином или бутадионом.
Большая или меньшая потливость отмечается почти всеми больными. Проливные ночные поты, заставляющие менять белье, часто сопровождают периоды лихорадки и указывают на тяжелое течение заболевания. Часто одним из симптомов заболевания является похудание.
Кожный зуд бывает приблизительно у 25-35% больных лимфомой Ходжкина. Его выраженность весьма различна: от умеренного зуда в областях увеличенных лимфатических узлов до распространенного дерматита с расчесами по всему телу. Такой зуд очень мучителен для больного лимфомой Ходжкина, лишает его сна, аппетита, приводит к психическим расстройствам.
Специфических для лимфомы изменений в клиническом анализе крови не существует. У большинства больных лимфомой Ходжкина отмечается умеренный лейкоцитоз. На поздних этапах, как правило, наблюдается снижение количества лимфоцитов в крови.
Диагноз "лимфома" устанавливается исключительно при гистологическом исследовании лимфатических узлов, полученных в результате операции, называемой биопсией пораженных лимфатических узлов или опухоли. Диагноз "лимфома" считается доказанным только в том случае, если при гистологическом исследовании найдены специфические многоядерные клетки Штернберга (синонимы – клетка Березовского-Штернберга или Штернберга-Рид). В сложных случаях необходимо иммунофенотипирование. Цитологического исследования (пункция опухоли или лимфатического узла) обычно недостаточно для установки диагноза.
- Биопсия лимфатического узла
- Общий анализ крови
- Биохимический анализ крови
- Рентгенография легких – обязательно в прямой и боковой проекциях
- Компьютерная томография средостения для исключения невидимых при обычной рентгенографии увеличенных лимфатических узлов в средостении в первом случае и поражения легочной ткани и перикарда
- Ультразвуковое исследование всех групп периферических, внутрибрюшных и забрюшинных лимфатических узлов, печени и селезенки, щитовидной железы при больших лимфатических узлах шеи
- Трепанбиопсия подвздошной кости для исключения поражения костного мозга
- Скенирование костей и при показаниях – рентгенография костей
Локальное поражение нескольких групп лимфатических узлов лимфомой Ходжкина можно излечить с применением лучевой терапии (облучения). Применение полихимиотерапии и комбинирование полихимиотерапии с лучевой терапией позволяют излечить пациентов и при генерализованном процессе (III-IV стадии заболевания).
Лучевую терапию в виде рентгенотерапии начали применять при лимфоме Ходжкина еще в 1902 году. Принципы излечивающей лучевой терапии впервые обосновал Гилберт в 1928 году. В последующем была предложена концепция радикальной лучевой терапии, при которой облучаются все лимфатические узлы. В настоящее время известны 2 модификации радикального облучения при лимфоме Ходжкина: многопольное, с последовательным облучением относительно большими полями пораженных лимфатических узлов и зон субклинического (не определяемого при обследовании) распространения, и крупнопольное, или мантиевидное, когда патологические и субклинические зоны облучаются практически одномоментно.
Крупнопольная методика облучения лимфомы Ходжкина требует четкой подготовки к лечению, сложных технических приспособлений. Однако по сравнению с многопольным методом применение мантиевидных полей позволяет сократить продолжительность курса лечения и избежать возникновения «горячих» зон на границах полей. Суммарная доза ионизирующего излучения, подводимая на опухоль, обычно составляет 36-40 Гр, время облучения одной зоны (лимфатических узлов выше или ниже диафрагмы) составляет от 3 недель до месяца. Специально разработанные для профилактики осложнений лучевой терапии методы позволяют пациентам достаточно легко переносить большие объемы лучевой терапии.
Лимфома Ходжкина стала одним из первых онкологических заболеваний, при котором была показана возможность излечения большой группы больных. Если в начале 40-х годов 5 лет переживало лишь 5% больных с лимфомой Ходжкина, то при использовании современных программ лечения двадцатилетняя безрецидивная выживаемость составляет 60%, а в группе больных с локальными стадиями достигает 80-90%.
Радикальная лучевая терапия длительное время была основным методом лечения I-III стадий лимфомы Ходжкина, но в настоящее время этот метод лечения успешно используется в группе больных с локальными стадиями и очень благоприятным прогнозом. Это небольшая группа больных с IA – IIА стадиями лимфомы Ходжкина, преимущественно женщины моложе 40 лет, без факторов риска. Полные ремиссии при использовании радикальной лучевой терапии индуцируются у 93-95% этих больных, 5-летнее безрецидивное течение достигает 80-82%, а 15-летняя общая выживаемость – 93-98%.
При применении только цикловой полихимиотерапии у больных с любой стадией лимфомы Ходжкина лечение следует проводить до достижения полной ремиссии, после чего необходимо провести, как минимум, два консолидирующих (закрепляющих) цикла. Полная ремиссия у больных лимфомой Ходжкина с благоприятным и промежуточным прогнозом после 3 циклов полихимиотерапии достигается не более чем у 50% больных, а у больных с распространенными стадиями заболевания этот рубеж преодолевается после 6 циклов полихимиотерапии, поэтому необходимый минимум всей программы лечения составляет не менее 6 циклов, но может достигать и 12 циклов.
При использовании только полихимиотерапии полные ремиссии достигаются у 70-85% больных лимфомой Ходжкина, а 20-летняя безрецидивная выживаемость составляет 60%. Однако у 40% больных лимфомой Ходжкина возникают рецидивы. В отличие от лучевой терапии, где рецидивы чаще возникают в новых зонах, после полихимиотерапии рецидивы чаще отмечаются в исходных зонах поражения.
Совмещение в одной программе лечения полихимиотерапии с лучевой терапией не только улучшило общую выживаемость больных лимфомой Ходжкина, но и позволило в 3-4 раза сократить число рецидивов (до 10-12%).
В процессе лечения у больных лимфомой Ходжкина могут развиваться нежелательные побочные явления как при проведении химиотерапии (общая слабость, тошнота, рвота, выпадение волос, снижение показателей крови, инфекции), так и лучевой терапии (покраснение кожи в поле облучения и другие). Правильное проведение процедур и следование рекомендациям лечащих врачей позволяют минимизировать количество осложнений от проводимого лечения лимфомы Ходжкина и не отказываться от привычного ритма жизни в ходе терапии.
Читайте также:
